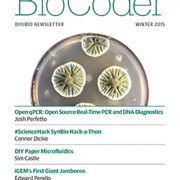
jeff balough's avatar

jeff balough (primehat23)
im metallic buttery's older cousin, like napoleon had a brother. I remember when Sha256 was shal and Nuclear power was a thing!
im metallic buttery's older cousin, like napoleon had a brother. I remember when Sha256 was shal and Nuclear power was a thing!